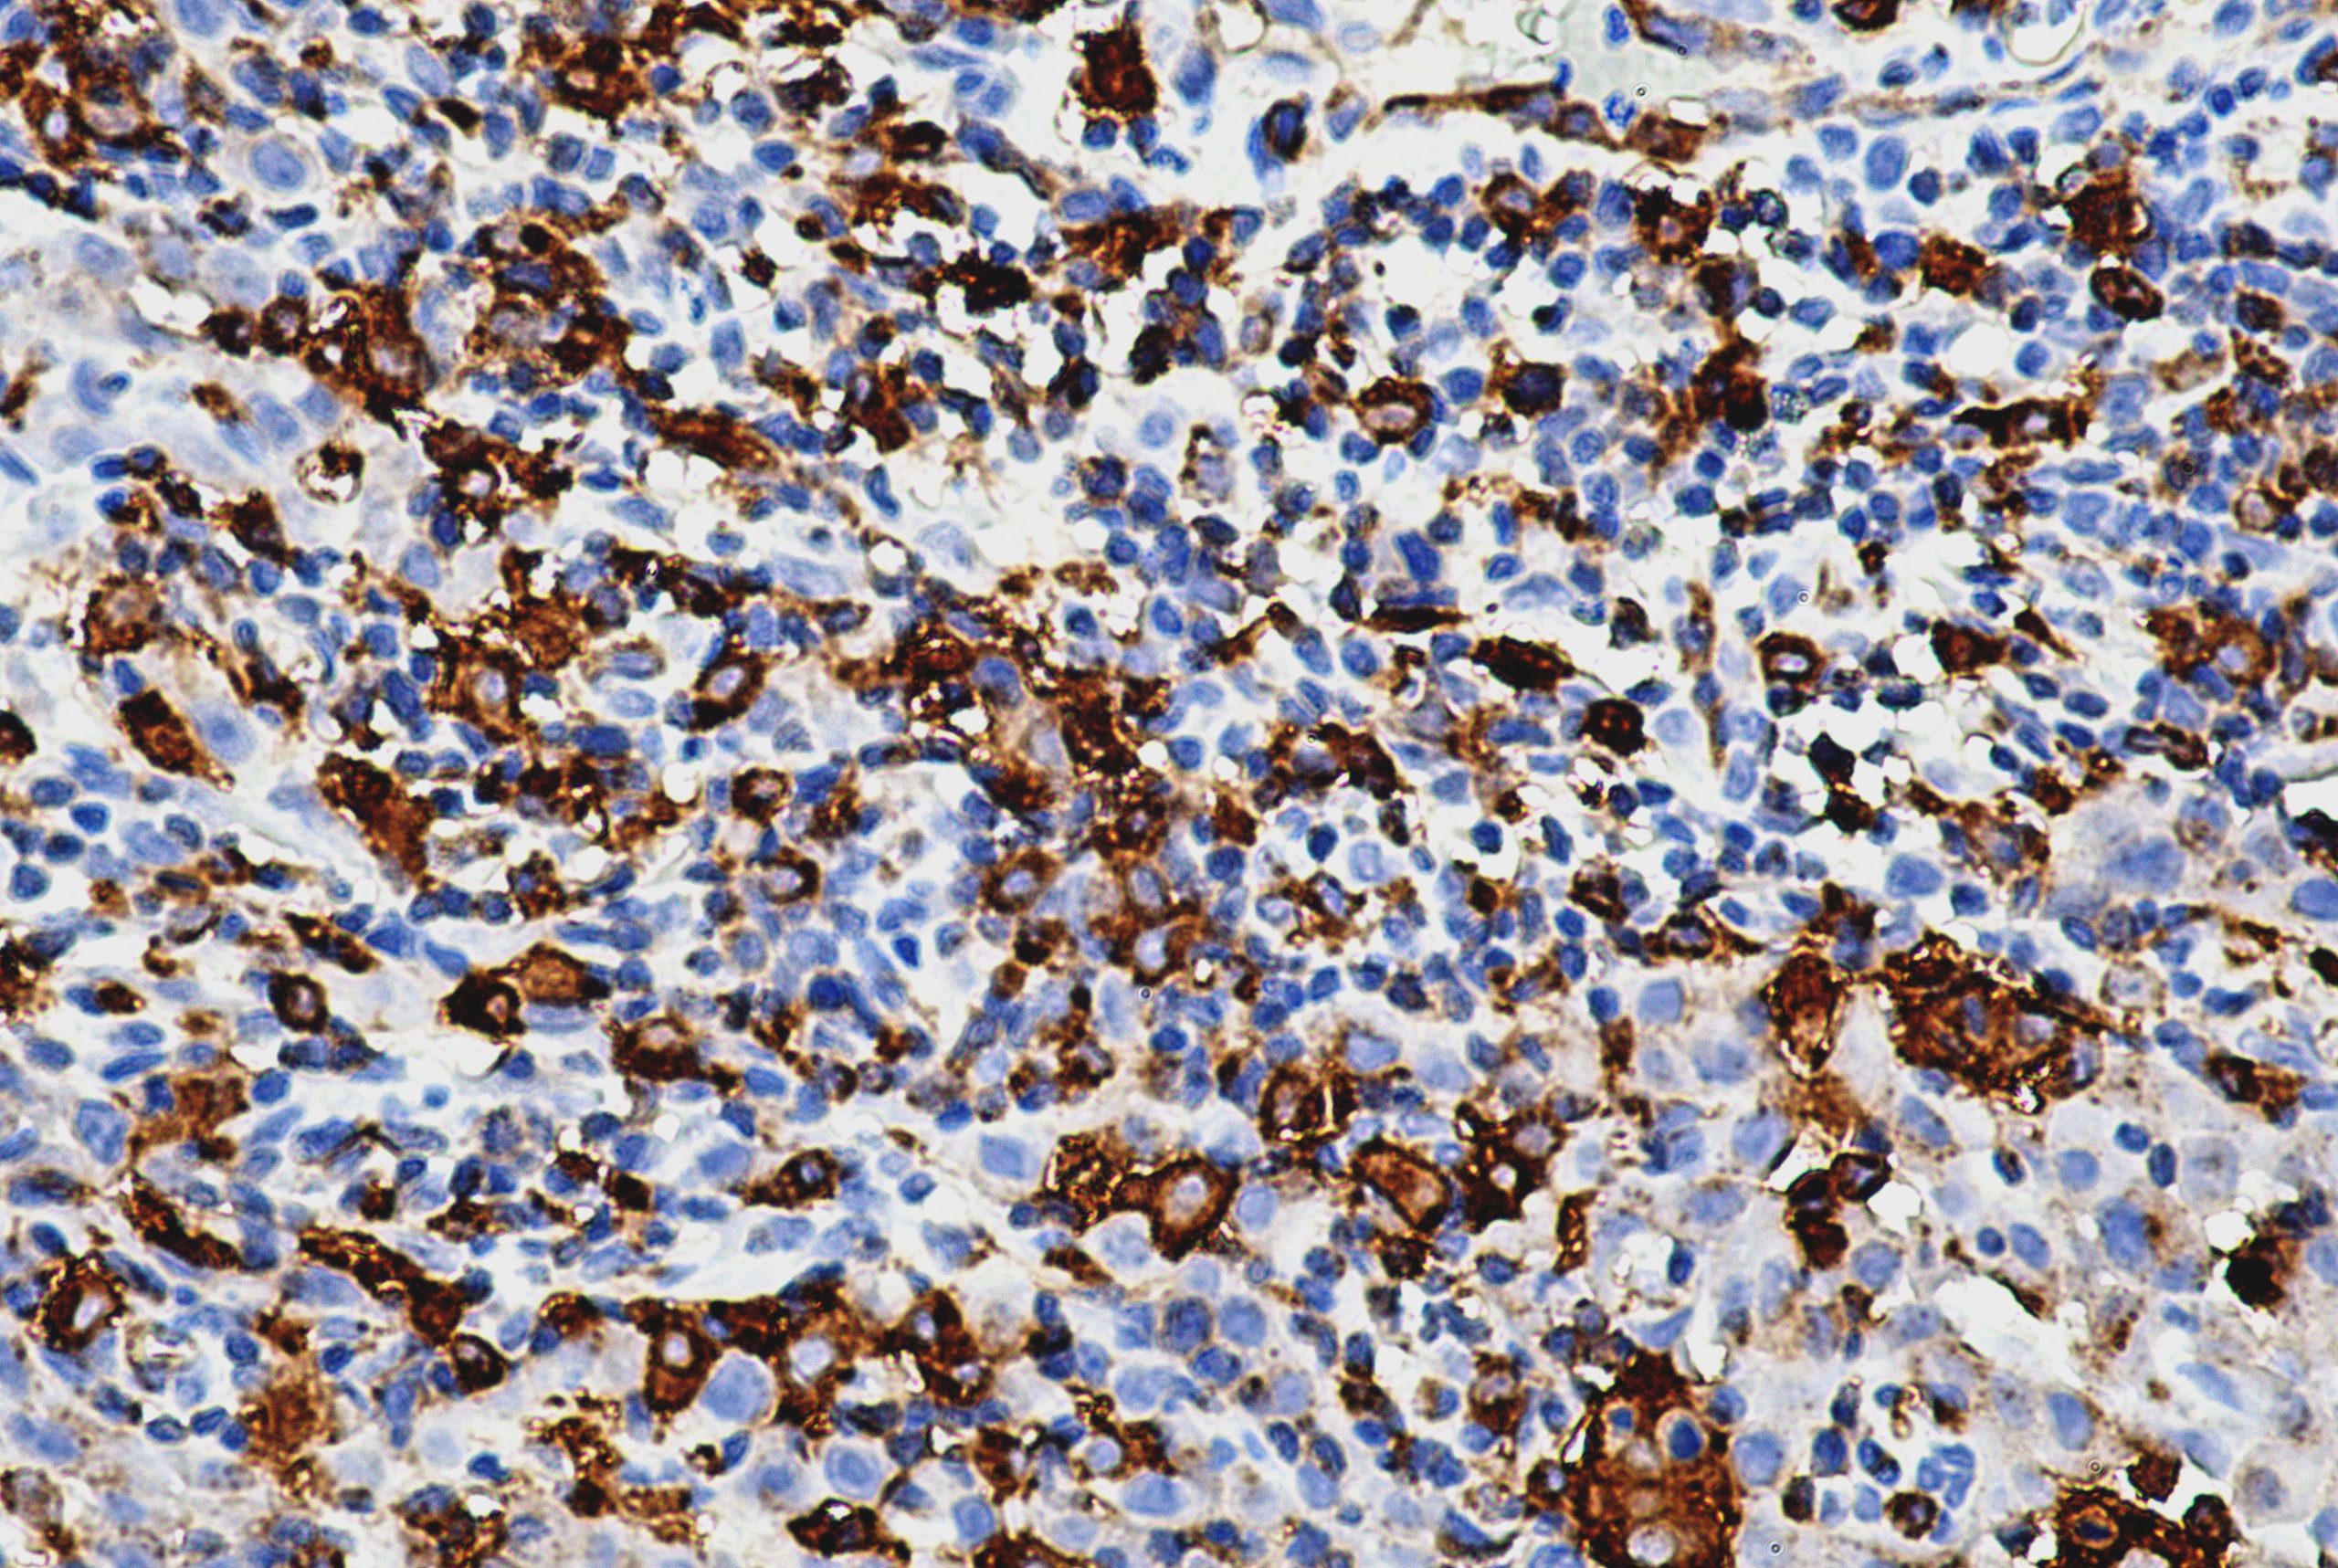
AMB53

Anti-HLA-DR/DP/DQ/DX, Clone CR3/43
HLA-DR/DP/DQ/DX antibody (also designated HLA class II HLADR / HLADP / HLADQ / HLADX antibody is a major histocompatibility complex (MHC) class II heterodimer cell surface receptor antibody. The major histocompatibility complex (MHC) is a large genomic region that has an important in the immune response to infections. The MHC class II molecules bind intracellularly processed peptides and present them to T-helper cells. These are expressed primarily on antigen presenting cells such as B lymphocytes, monocytes, macrophages, and thymic epithelial cells and are also present on activated T lymphocytes.
| Intended Use | IVD |
|---|---|
| Antibody Type | Monoclonal |
| Clone | CR3/43 |
| Source | Mouse |
| Tissue Type/Cancer Type | Lymph Node tissue |
| Pack | 0.5 mL – Manual – Concentrate, 1 mL – Manual – Concentrate, 6 mL – Manual – RTU, 50 Tests – Automation – Xmatrx, 100 Tests – Automation – i6000, 160 Tests – Automation – Xmatrx, 5 slides – Xmatrx, 5 slides – Manual, 50 tests – NanoVIP® |